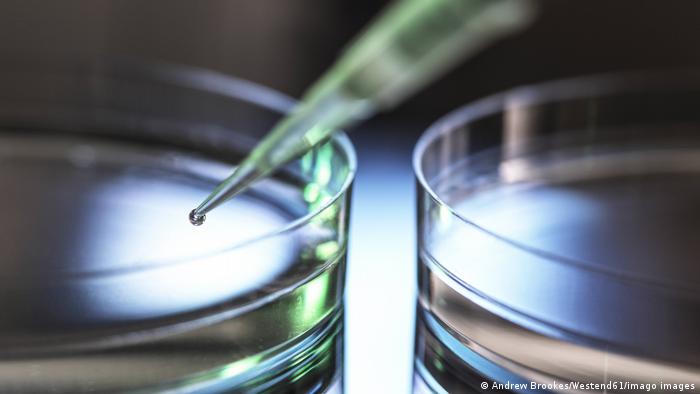

En ensayos de laboratorio, el anticuerpo MCLA-158 bloqueó la expansión del cáncer a otros órganos y frenó el crecimiento de tumores primarios en ratones.
Un consorcio internacional liderado por Eduard Batlle, científico del Instituto de Investigación Biomédica (IRB) de Barcelona, descubrió el anticuerpo MCLA-158, el primer candidato a fármaco dirigido a células madre cancerosas de tumores sólidos que previene la propagación del cáncer y la metástasis.
Batlle, jefe del laboratorio de Cáncer Colorrectal del IRB, en colaboración con la empresa biotecnológica holandesa Merus N.V., publicó en la revisa 'Nature Cancer' los datos preclínicos que han conducido al descubrimiento de MCLA-158 y su mecanismo de acción sobre las células madre del cáncer.
Según informa el IRB en un comunicado, con el nombre comercial de Petosemtamab, el anticuerpo MCLA-158 bloquea la expansión del cáncer a otros órganos y frena el crecimiento de los tumores primarios en ratones a los que han implantado células tumorales de pacientes con cáncer de colon.
La investigación, además, sienta las bases para incorporar el uso de organoides en el proceso de descubrimiento de fármacos.
Remisiones en pacientes humanos
Los organoides son muestras derivadas de pacientes que se pueden cultivar y que reproducen el comportamiento del tumor en el laboratorio.
Hasta ahora, exploraban su utilidad en la medicina personalizada del cáncer, pero para descubrir el MCLA-158, por primera vez utilizaron un biobanco de organoides de pacientes con cáncer para discriminar entre cientos de nuevos anticuerpos cuál de ellos era más efectivo y adecuado para la mayoría de los pacientes.
En octubre de 2021, Merus publicó datos preliminares sobre el análisis de la eficacia del anticuerpo, basados en su ensayo clínico, aún en curso, de fase 1 de expansión de dosis.
En este ensayo clínico se investigan la seguridad, tolerabilidad y actividad antitumoral de la monoterapia con MCLA-158 en carcinomas de células escamosas de cabeza y cuello (HNSCC).
En el ensayo, tres de siete pacientes con HNSCC lograron remisiones parciales, y uno de ellos logró una remisión completa, mientras que en los siete pacientes hubo una reducción del tumor.
Células madre sanas, a salvo
El anticuerpo descrito en este trabajo, el Petosemtamab (MCLA-158), es un anticuerpo biespecífico que reconoce dos proteínas distintas en las células madre del cáncer, la EGFR y la LGR5.
"Este anticuerpo, además, no interfiere con el funcionamiento de las células madre sanas del organismo, que son esenciales para el buen funcionamiento de los tejidos", según Batlle.
Los datos preclínicos indican que el anticuerpo MCLA-158 muestra una potente inhibición del crecimiento de los organoides del cáncer colorrectal, bloquea el inicio de la metástasis y el crecimiento del cáncer en diferentes modelos de tumores, entre ellos de cabeza y cuello, esófago y estómago.
En esta investigación participaron también el Instituto Hubrecht, el Instituto Sanger, las empresas Ocello BV/Crown Bioscience y Xenopat, el Vall d'Hebron Instituto de Oncología (VHIO), el Instituto Catalán de Oncología (ICO), el Instituto de Investigación Biomédica de Bellvitge (IDIBELL).
EL(efe)